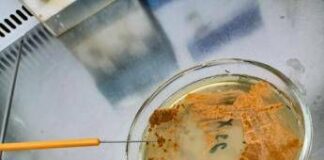
UnInsubria, scoperto nuovo antibiotico contro superbatteri

Tag: salute
Jovanotti e la dieta Omad, cos’è e perché non è per...
(Adnkronos) - L'ultimo è Jovanotti, che ha rivelato in collegamento con la trasmissione di Fiorello
di mangiare una sola volta al giorno. Ma negli...
Muscoli mai in vacanza, 2 settimane di sgarri in estate vanificano...
(Adnkronos) - Per rimanere sani, tonici e definiti, i muscoli non dovrebbero mai andare in vacanza. Bastano infatti anche solo 2 settimane di assoluto...
Disturbi tiroide per 6 mln italiani, speranza Ia per diagnosi e...
(Adnkronos) - In occasione della Giornata mondiale della tiroide, in programma il 25 maggio, l'Associazione medici endocrinologi (Ame) partecipa con le principali società scientifiche...
Chirurgia, restituito l’udito a un bimbo di 2 anni, intervento record...
(Adnkronos) - Un bimbo di 2 anni nato senza i nervi dell'udito, "un'assenza bilaterale rarissima", ora può sentire grazie a un intervento eseguito all'ospedale...
Vaia: “Scatto deciso e forte per rilanciare Ssn, lo chiedono Mattarella...
(Adnkronos) - "Serve uno scatto deciso e forte per rilanciare il nostro Servizio sanitario nazionale, come chiede da tempo il nostro presidente Mattarella, interpretando...
Giornata sollievo, infermieri: “Valorizzare nostro ruolo nelle cure palliative”
(Adnkronos) - "L'infermiere previene, rileva e documenta il dolore della persona assistita durante il percorso di cura. Si adopera per la gestione del dolore...
Cheratocongiuntivite primaverile, cos’è e perché le lacrime ‘raccontano’ la malattia
(Adnkronos) - Una lacrima sul viso può raccontare molto, anche da un punto di vista clinico. Soprattutto se raccolta con il test di Schirmer:...
Sta per prendere il via il Tour della Salute 2025
(Adnkronos) -
In collaborazione con/author: Ben Reichert
La parola d'ordine della settima edizione del Tour della Salute? Prevenzione. Nel 2025 l'evento toccherà 15 città italiane,...
UnInsubria, scoperto nuovo antibiotico contro superbatteri
(Adnkronos) - Un gruppo di ricerca internazionale coordinato dall'università degli Studi dell'Insubria, guidato da Flavia Marinelli del Dipartimento di Biotecnologie e scienze della vita,...
‘Bodybuilder a rischio morte improvvisa’, appello scienziati per screening
(Adnkronos) - Muscoli forti, cuore debole. I bodybuilder maschi rischiano la morte improvvisa, specie i professionisti che corrono un pericolo più che quintuplo rispetto...